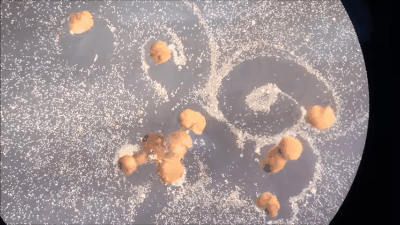
全球首个“自我繁衍”的活体机器人诞生：真那么神奇？

活久见!全球首个活体机器人创生命繁衍新方式!
大家印象中的机器人是不是还停留在铜头铁额的机械体?
亦或是由钢筋混凝土或者粗重木头制成的庞然大物?
这不,科学家马上安排了一批活体机器人,划重点,全球首批!
而且,这些机器人还会自我繁殖......
这是由来自佛蒙特大学、塔夫茨大学以及哈佛大学Wyss研究所的科学家们发现的一种全新生物繁殖形式,并创造了有史以来第一个「自我复制」的活体机器人。
目前,这项研究成果已于2021年11月29日发表在《美国国家科学院院刊》(PNAS)上。

去年,这批学者就依靠进化算法,利用青蛙的表皮细胞和心肌细胞造出了全球首批活体机器人,并将其命名为「Xenobot」。
不同于传统机器人,也不是已知的某种动物物种,「Xenobot」是一种新型的、具有生命的、可编程的生物,而且可以自主移动,即使被切开也能够自动愈合。

自主移动的Xenobot

自动修复的Xenobot










